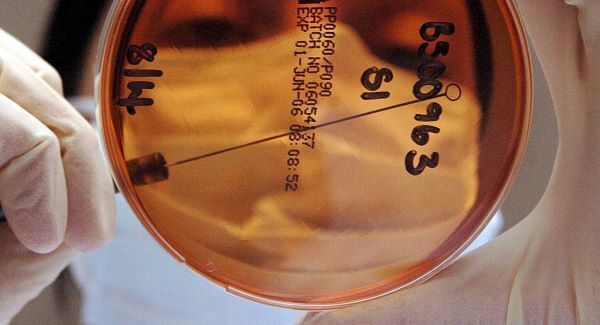

The Briefing - Your Thursday morning news catch up
BRIEFING TOP STORY

The anti-water charges campaign has crossed the Atlantic after six Irish holidaymakers took advantage of an in-store promotion to have a message to the Taoiseach flashed up in New York’s Time Square.
READ MORE
IRISH NEWS

Get your skis on — it’s time to go on the piste on the northside of Cork City.
READ MORE
A man in his 40s was stopped and questioned at Dublin Port yesterday while he was attempting to board a ferry to Holyhead with a large amount of cash.
READ MORE
WORLD NEWS
A drug that kills cancer cells as they try to divide has shown "dramatic" results in early research, paving the way to potentially curative treatments.
READ MORE
A masked gunman who killed a soldier at Canada’s war memorial and stormed parliament before being shot dead by the ceremonial sergeant-at-arms was an Islamic convert, it has emerged.
READ MORE
SPORT

Expected it may have been but Cristiano Ronaldo and Real Madrid still delivered a brutal and demoralising reminder of where Liverpool stand amongst Europe’s elite.
READ MORE
Manager Arsene Wenger is confident Arsenal can use their dramatic stoppage-time victory at Anderlecht as a springboard to secure qualification for the knockout stages of the Champions League once again.
READ MORE
BUSINESS

Team Juncker roared past the finishing post in the European Parliament, right on schedule, promising to present a €300 billion plan for investment, growth and jobs within six weeks.
READ MORE
VIEWPOINTS

830,000 babies die every year because they weren’t even breast-fed for an hour
READ MORE
EXAMVIRAL
Looking for a unique Halloween costume to stand out from the crowd of zombies? Best avoid these ones...
READ MORE
SHOWBIZ

Chart-topping soul singer Sam Smith dedicated his triumph to his parents after celebrating being the big winner at the Mobo Awards.
READ MORE
TOP FEATURES

They are some of the sharpest sleuths in the Revenue Commissioners’ arsenal. goes to Cork Airport to learn how sniffer dogs go about their job
READ MORE
MOST READ RIGHT NOW ...

The Hurling 2020 committee is expected to recommend penalties be changed from the current one forward versus three defenders on the goal-line to one forward versus the goalkeeper.
jeanClaudeJunckerPointing


